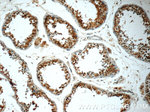
MUM1L1 Antibody in Immunohistochemistry (Paraffin) (IHC (P))

Search
Proteintech
MUM1L1 Polyclonal Antibody
{{$productOrderCtrl.translations['antibody.pdp.commerceCard.promotion.promotions']}}
{{$productOrderCtrl.translations['antibody.pdp.commerceCard.promotion.viewpromo']}}
{{$productOrderCtrl.translations['antibody.pdp.commerceCard.promotion.promocode']}}: {{promo.promoCode}} {{promo.promoTitle}} {{promo.promoDescription}}. {{$productOrderCtrl.translations['antibody.pdp.commerceCard.promotion.learnmore']}}
产品信息
24762-1-AP
种属反应
宿主/亚型
分类
类型
抗原
偶联物
形式
浓度
规格
纯化类型
保存液
内含物
保存条件
运输条件
产品详细信息
Immunogen sequence: IAASLGLQS EDSAPPTEET AYGRSLKVAL GILNERTNLS QASTSDEEEI TMLSQNVPQK QSDSPPHKKY RKDEGDLPGC LEERENSACL LASSESDDSL YDDKSQAPTM VDTIPSEVET KSLQNSSWCE TFPSLSEDND EKENKNKIDI SAVMSVHSAV KEESACVKDE KFAPPLSPLS SDMLIMPKAL KEESEDTCLE TLAVPSECSA FSENIEDPGE GPSNPCLDTS QNQPSMESEM GAAACPGSCS RECEVSFSAS NPVWDYSHLM SSERNFQRLD FEELEEEGQA SDKSLLPSRI NLSLLDDDE (66-373 aa encoded by BC109292)
靶标信息
The MUM1L1 (Melanoma Associated Antigen (Mutated) 1-Like 1) gene encodes a protein that is a member of the PWWP domain-containing family and is thought to be involved in chromatin organization and gene expression regulation. Located on chromosome Xq22.3, MUM1L1 shares homology with the oncogene MUM1, known for its roles in cancer biology, particularly in multiple myeloma and lymphomas. The PWWP domain of MUM1L1 is implicated in binding histone methylation marks, thereby influencing transcriptional activity. Although the precise biological function of MUM1L1 remains to be fully elucidated, its expression patterns suggest a role in cell proliferation and differentiation.
仅用于科研。不用于诊断过程。未经明确授权不得转售。
篇参考文献 (0)
生物信息学
蛋白别名: melanoma associated antigen (mutated) 1-like 1; MUM1 like 1; MUM1-like protein 1; Mutated melanoma-associated antigen 1-like protein 1; PWWP domain-containing DNA repair factor 3B; PWWP domain-containing protein MUM1L1; PWWP3B; unnamed protein product
基因别名: MUM1L1; PWWP3B
UniProt ID: (Human) Q5H9M0
Entrez Gene ID: (Human) 139221